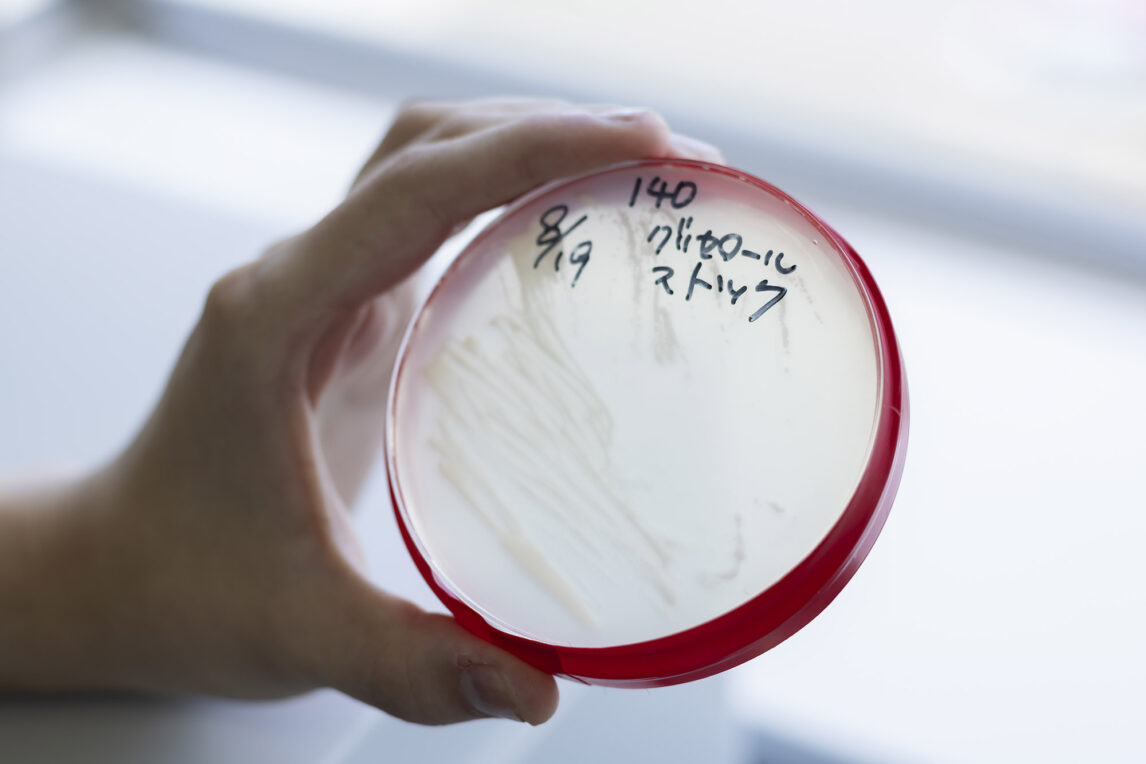

[卒業研究 北海学園ワイン プログラム]
工学部 生命工学科4年 田中 あずみ
工学部 生命工学科4年 岩田 大輝
(写真左から)
ワイン界の大谷翔平選手を探せ!
——お二人が取り組んでいる卒業研究の内容について教えてください。
【岩田】生命工学科では、北海道ならではの「土地の個性」を感じられるワイン造りを目指して、2017年から「野生酵母」を単離し、ワイン造りに合う酵母を選抜するという研究を続けています。
【田中】私たちの代では、先輩たちが北海道中を駆け回って集めた数百もの酵母株の中から、赤ワイン用ブドウ品種「ピノ・ノワール」と白ワインを造るブドウ品種「ナイアガラ」に合う酵母株をそれぞれ選抜し、いろいろなテストを通して、大谷翔平選手のような優秀な酵母株を探し出す研究を行っています。

【岩田】ワインはブドウ果汁から造られますが、ブドウ果汁がワインになるには酵母という微生物の働きが関係しています。ブドウ果汁に含まれる糖を、酵母がアルコールと炭酸ガスに分解することでワインができるのですが、酵母はワインの風味や味わいなどの品質にも影響を与えます。ですから、ワイン造りにおいて酵母株選びはとても重要と言えます。
【田中】そもそも酵母というのは、実は自然界にものすごくたくさん存在しています。目には見えませんが、机の上にも、靴の裏にも、畑の土にも、ブドウの果皮にも付着しています。ですが、ワイン造りに向いている酵母株というのは、ごく限られています。多くのワイナリーでは、ワイン用にあらかじめ選抜された「純粋酵母」と呼ばれるものを海外から買ってワインを造るのですが、「安く」「飲みやすい」ワインが手に入るようになった一方で、「特徴のない」「没個性」のものが多い、とも言われています。
——大谷選手を探す! 面白そうですが、具体的にはどういう研究でしょうか。
【岩田】例えば酵母株の中には、自分がつくったアルコールで死んでしまうような弱い酵母株がいたり、発酵するのにものすごく時間のかかってしまう酵母株もいたりします。まずはその酵母株がワイン造りに向いているかどうかを、さまざまな実験を通して見極め、選抜します。次に、そうして絞り込んだ酵母株を使って、少量ではありますが実際に醸造し、どんな味のワインができるかをチェックします。最終的には僕たち学生と先生、八剣山ワイナリーの方を交えて官能試験(テイスティング)をして候補を赤・白各一つに絞り込み、ワイナリーさんがその酵母株を使ってワインを仕込みます。
手がけたワインは、いつか知らない誰かのもとへ。
——まだ卒業研究としては途中段階ですが、これまでを振り返っていかがでしょうか。
【田中】酵母株によって発酵スピードに思った以上の差があったり、酵母株の培養がうまくいかず計画した通りに進まなかったりすることも多く、難しさを感じています。
【岩田】でも、判断に迷うときはお互いに相談したり、実験結果を踏まえて次にどうするか意見を出し合ったり。仲間と協力して一つのものごとを進めるのは楽しいですね。
【田中】これまでも実験の授業でほかの学生と一緒に作業を進めることはあったけれど、卒業研究はそれに比べて期間もずっと長く、チームワークの大切さを感じています。

——誰かと協力しながら一つのプロジェクトを進めた経験は、社会に出てから役立ちそうですね。岩田さんは、卒業研究を通して何か感じたことはありましたか?
【岩田】新沼ゼミの学生が集まって2~3週間に一度、進捗報告という卒業研究の中間報告を行う場があるのですが、みんながみんなワインに詳しいわけではないので、発表するときには専門的な知識がなくてもわかるような言葉を選び、伝わりやすい発表資料を作成することを心がけています。こうした「人に分かりやすく伝える」という意識付けは社会に出ても大事になってくると思いました。
——この研究の面白さはどんなところにありますか?
【岩田】実験そのものも楽しいのですが、先日、チ・カ・ホ(札幌駅前通地下広場)で八剣山ワイナリーの販売イベントがあり、お客さんが学園オリジナルワインを手に取って吟味していました。そのワイン自体は、自分たちの代ではなく先輩が造ったものですが、それでもすごくうれしくて。僕たちが手がけたワインも、いつかこうやって自分の知らない誰かのもとへ届くんだと想像したら、とてもワクワクしました。
【田中】私の父も「絶対に買う」と言って完成をすごく楽しみにしてくれています。


卒業研究で得た力を卒業後も。
——お二人はそれぞれ卒業後の進路も決まっているそうですね。
【田中】札幌市の採用試験に合格しました。技術職ではなく、一般事務です。卒業研究そのものは、これからの仕事に直接関係ないかもしれないけれど、実験を行う中で思うような結果が出なかったときに、どうして失敗したんだろう? どの段階で失敗したんだろう? と分析する力を養えたことは、事務職でも生きてくるのかなと思います。
【岩田】僕は製パン会社への就職が決まりました。就活の時点では品質管理の仕事がしたいと考えていましたが、実際にワインの研究開発を経験した今は商品開発にも興味があります。学園オリジナルワインを購入しているお客さんの顔を見て、その気持ちが強くなりました。

——最後に、北海学園大学への受験を考える方へメッセージをお願いします。
【岩田】僕らが入学した2021年はコロナ禍で対面授業がほとんどなく、学校に行くこともほぼありませんでした。なので文系の人たちと交流する機会もなかったんです。だから、これから入学するみなさんはうらやましいですよね。北海学園大学は道内最大規模の私立大学で在学生も多いので、学部を超えてめいっぱい交流して、いろんな人に出会ってほしいと思います。道内津々浦々にたくさんの先輩がいるので、人脈を築きたい方にはおすすめです。就職に強いというのも北海学園大学の魅力だと思います。
【田中】生命工学科は、バイオと情報の二つの領域を学べることが一番の特徴です。やりたいことが決まっていない人にとっては、就職先として食品製造やバイオ系にも行けるし、情報系も選べるし、大学の公務員講座も充実しているので公務員を目指すことも。選択肢が多いというのは、やっぱり生命工学科の魅力だなって思います。
